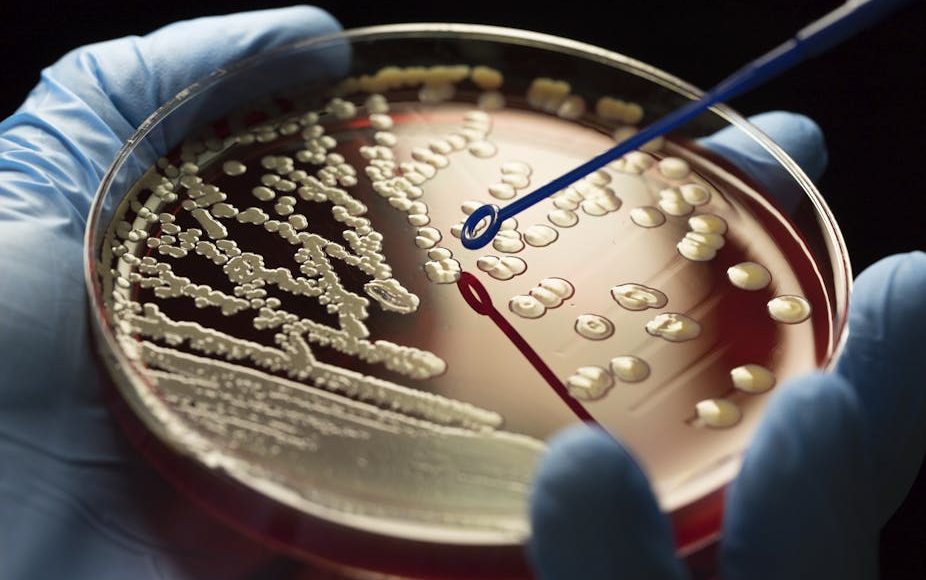

Les antibiotiques, découverts au milieu du XXᵉ siècle, ont transformé la médecine moderne. Ces médicaments ont permis de traiter des infections bactériennes autrefois mortelles, sauvant des millions de vies à travers le monde. Cependant, une menace croissante assombrit cet héritage : la résistance aux antibiotiques. Ce phénomène, selon des experts en santé publique, compromet notre capacité à traiter des maladies courantes, menaçant ainsi la santé mondiale.
Une révolution médicale sous pression
Les spécialistes en histoire de la médecine qualifient la période entre les années 1940 et 1960 d’« âge d’or » des antibiotiques. Ces médicaments ont permis de vaincre des infections graves comme la tuberculose ou la pneumonie, offrant un tournant décisif dans la lutte contre les maladies infectieuses. Mais aujourd’hui, leur efficacité diminue. Des scientifiques attribuent cette crise à une utilisation excessive ou inappropriée, tant en médecine humaine que dans l’élevage.
Le rôle de l’élevage industriel
Selon des experts en santé animale, près de 70 % des antibiotiques produits dans le monde sont destinés aux animaux d’élevage. Utilisés pour prévenir des maladies liées à des conditions d’hygiène souvent insuffisantes, ces antibiotiques favorisent l’émergence de bactéries résistantes. Ces dernières peuvent ensuite se transmettre à l’homme, notamment par la chaîne alimentaire. Des spécialistes en réglementation internationale signalent que l’utilisation des antibiotiques dans l’élevage varie selon les pays, reflétant des différences dans les pratiques agricoles et les lois en vigueur.
Un défi global, des solutions urgentes
Les épidémiologistes estiment que des actions coordonnées sont indispensables pour endiguer ce phénomène. Ils soulignent la nécessité d’une régulation plus stricte de l’utilisation des antibiotiques, tant en médecine humaine que vétérinaire. Les professionnels de santé doivent prescrire ces médicaments avec discernement, tandis que les experts en sensibilisation publique insistent sur l’importance d’éduquer les citoyens pour éviter l’automédication.
Par ailleurs, des microbiologistes plaident pour un investissement accru dans la recherche de nouveaux antibiotiques et d’alternatives thérapeutiques. Selon eux, la baisse des financements ces dernières années a freiné l’innovation. En parallèle, des spécialistes en technologie médicale estiment qu’il est urgent de développer des outils de diagnostic rapides et précis pour mieux cibler les traitements et réduire leur usage systématique.
Un avenir en équilibre
Si rien n’est fait, préviennent des analystes en santé mondiale, les infections résistantes pourraient causer jusqu’à 10 millions de décès par an d’ici 2050. La préservation de l’efficacité des antibiotiques dépend d’une mobilisation mondiale, englobant gouvernements, professionnels de santé et citoyens.
La résistance aux antibiotiques n’est pas une fatalité. Mais comme le rappellent les experts, il est urgent de réagir pour éviter que cette révolution médicale ne devienne un lointain souvenir.
Tinhinane B